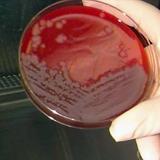
¿Qué es el ántrax o carbunco?

Un nuevo foco de carbunco en vacuno, el tercero en un mes en Extremadura
Se ha localizado también en el municipio pacense de La Codosera
Además de lengua azul, el carbunco o ántrax en vacuno aparece en Extremadura. Son tres focos ya de esta enfermedad en el periodo de un ... mes. Según ha confirmado el Laboratorio de Algete, el último caso confirmado hace unos días se vuelve a situar en el municipio pacense de La Codosera.
La web del Registro de Sanidad Veterinaria indica que se ha detectado carbunco en una explotación de vacas de ese municipio fronterizo con Portugal. Hace un mes, 9 bovinos murieron por otro foco declarado en La Codosera.
A este se une el caso, adelantado por HOY, la semana pasada en Valverde de Mérida, con más de una decena de animales muertos por esta enfermedad.
El ántrax es una enfermedad causada por la bacteria Bacillus anthracis formadora de esporas. Las esporas de ántrax en el suelo son muy resistentes y pueden causar enfermedades cuando se ingieren incluso años después de un brote.
¿Tienes una suscripción? Inicia sesión